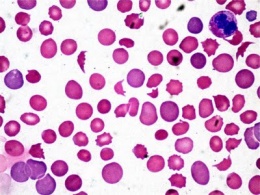
Anemia autoinm.jpeg

Anemia inmunohemolítica
| ||||||||||
Anemias inmunohemolíticas, son un grupo de anemias hemolíticas poco frecuentes causadas por enfermedades autoinmunes en donde el sistema inmune ataca a los glóbulos rojos.
Sumario
La hemólisis
Su hemólisis puede ser intravascular (mediada por complemento o extravascular (en el sistema reticuloendotelial por inmunidad celular.También se llama anemia hemolítica inmunocompleja y anemia hemolítica autoinmune.
Anemia Inmunohemolítica por Anticuerpos Calientes
Éstos suelen ser anticuerpos (rara vez en combinación con IgM y IgA que tienen la peculiaridad de activarse a la temperatura del cuerpo. Es más frecuente en mujeres adultas que en otros grupos, en enfermedades inmunes (lupus eritematoso sistémico) aunque suele ser idiopática. Los eritrocitos marcados por los autoanticuerpos (opsonización) son destruidos en el bazo por fagocitos y por activación del complemento (C3b y C4b), por lo que la hemólisis puede ser intravascular como extravascular. La enfermedad varía de pacientes asintomáticos a sus forma más grave de hemólisis fulminante. La Prueba de Coombs Directa es Positiva en más del 98% de los casos. El tratamiento de los casos leves y graves consiste en administrar Glucocorticoides (Prednisona) y/o inmunosupresores.
Anemia Inmunohemolítica Secundaria a Fármacos
Ciertos fármacos como el antihipertensivo alfa metildopa forman complejos inmunogénicos (IgG) causando una hemólisis que puede ser grave. Los defectos ceden al interrumpir la administración del medicamento. El Anticuerpo se detecta con la Prueba de Coombs.
Anemia Inmunohemolítica por Anticuerpos Fríos
Éstos suelen ser anticuerpos IgM que tienen la peculiaridad de activarse a temperaturas menores de 37 ºC, y por ello el nombre de "Crioglobulinas". Aparecen secundarios a una Neoplasia (linfoma, leucemia linfoide crónica , [[linfadenopatía angloinmunoblástica]] o en respuesta a una infección(por Micoplasma neumoniae,citomegalovirus,VIH y en la Mononucleosis Infecciosa). Las manifestaciones clínicas aparecen cuando el paciente se expone al frío (alimentos o bebidas frías): Acrocianosis o fenómeno de Raynaud (coloración purpúrea intensa de los miembros, orejas y nariz, cuando las sangre se enfría lo suficiente como para aglutinarse en los pequeños vasos) y desaparece al calentar las partes afectadas. Ciertos anticuerpos monoclonales han sido eficaces en el tratamiento de anemias por crioaglutininas.
Síntomas
- Fatiga
- Palidez de la piel
- Dificultad respiratoria
- Taquicardia
- Orina turbia
- Agrandamiento del bazo (esplenomegalia)
Diagnóstico
- Prueba de Coombs directa o indirecta positiva10
- Niveles de bilirrubina elevados
- Nivel elevado de LDH (enzimas cuyos niveles se elevan como resultado del daño tisular)
- Haptoglobina sérica baja
- Hemoglobina en la orina
- Aumento en el conteo de reticulocitos absoluto11
- Conteo de glóbulos rojos y hemoglobina bajo (hematocrito)
Véase también
Fuentes
- Rinaldo, BENCOMO HERNANDEZ, Antonio et al. Determinación de anticuerpos antinucleares en la anemia hemolítica autoinmune y la púrpura trombocitopénica autoinmune. Rev Cubana Hematol Inmunol Hemoter, ene.-abr. 2002, vol.18, no.1, p.0-0. ISSN 0864-0289.[3]